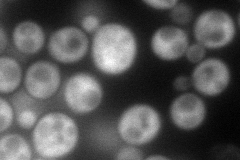
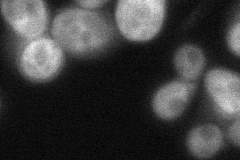
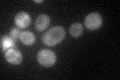

View description
AMP deaminase, tetrameric enzyme that catalyzes the deamination of AMP to form IMP and ammonia; may be involved in regulation of intracellular adenine nucleotide pools
Localization:
Intensity:
Fold change:
Significance:
-
C’ GFP library in SD

cytosol54.82 -
N' NOP1pr-GFP in SD
cytosol120.185 -
N' TEF2pr-mCherry in SD

cytosol172.619 -
N' NATIVEpr-GFP in SD
cytosol52.7864 -
N' TEF2pr-VC and Cyto-VN in SD

#N/A0 -
C’ GFP library in SD+DTT

cytosol61.071.11No -
C’ GFP library in SD+H2O2

cytosol56.731.03No -
C’ GFP library in Starvation Media
cytosol73.941.34Yes -
C’ GFP library on the background of Pup2-DaMP

cytosol -
C’ GFP library on the background of CCT mutant

cytosol51.24330.934669No
